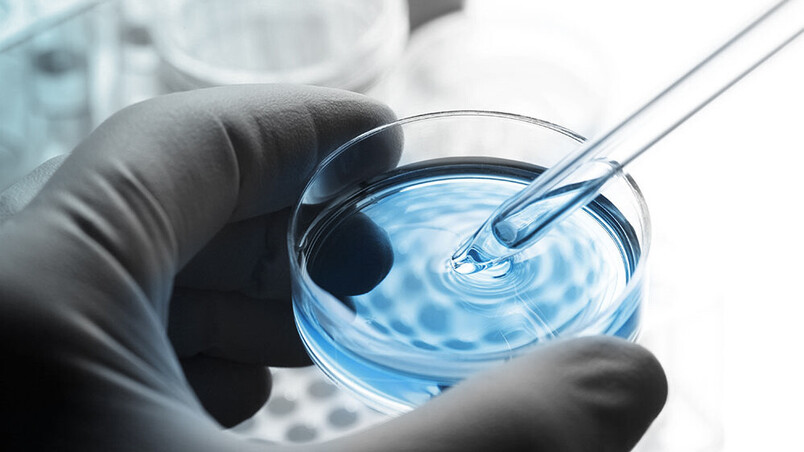

小規模研究室で最高のパフォーマンス

Cat.No.:1802
| Max. RCF | Max. RPM | 寸法(幅×奥行×高さ) | 最大容量 | 重量 |
| 6,153 | 8,000 min-1 | 261 x 353 x 228 mm | 8 x 15 ml | 約 11 kg |
小規模研究室で最高のパフォーマンス
EBA 200 Sは、少量サンプルの分析に適した実用的でコンパクトな遠心分離機です。高速Sモデルは、3分以内で信頼性の高い結果を提供します。8つの固定角度付きローターが付属しており、最大15ml容量の標準的な血液および尿チューブを収容できます。
応用分野

臨床
- アングルローターを内蔵しており、採血管や尿管の低スループット処理に最適です。
パッケージ

パッケージの内容
- 1x | 1802 | EBA 200 S 遠心分離機
- 1x |統合|アングルローター、8ヶ所
- 8x | 1054-A | アダプタ、1箇所
- 8x | 1058 | アダプタ、1箇所
上記のパッケージに加え、EBA 200 Sは22種類以上の構成に対応しています。当社の遠心分離機パッケージは最も人気のある構成を網羅しており、ご注文も簡単です。遠心分離機バンドルには、遠心分離機、ローター、バケット、アダプタが同梱されており、お客様のアプリケーションに必要なすべてのものが含まれています。
| チューブ数量 | 容量(ml) | サイズ(mm) | 回転数 | RCF |
| 8 | 1.1 – 6 | 13×75 | 8,000 | 4,794 |
| 8 | 4~7 | 13×100 | 8,000 | 6,153 |
品番: 1802SET1